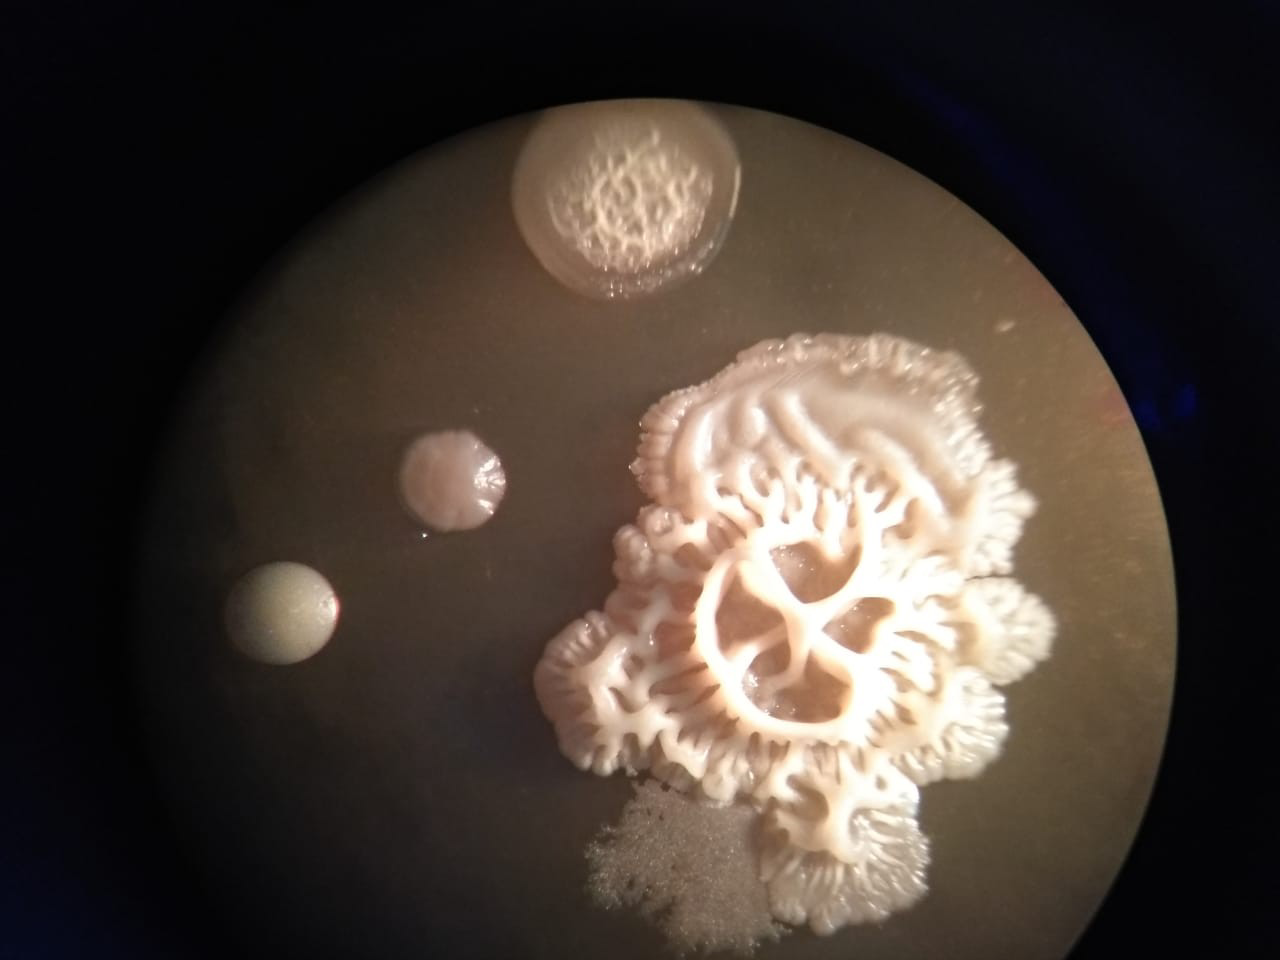

Загрязнение почв тяжелыми металлами относится к одним из самых распространенных последствий человеческой деятельности: металлы содержатся в отходах и выбросах промышленных предприятий, а также в выхлопных газах автомобилей. Попадая в окружающую среду, они накапливаются в почвах, водоемах и живых организмах, а далее могут передаваться по пищевым цепям и человеку. Один из самых распространенных металлов-загрязнителей — медь.
Поэтому исследовательская группа из Южного федерального университета (Ростов-на-Дону) оценила его влияние на качество органического вещества, образующегося в почве после разложения тканей растений и животных. Также авторы рассмотрели изменения активности ферментов — белков, ускоряющих химические реакции в живых организмах, — и микробного состава почвы, в прошлом подверженной выбросам промышленных предприятий. Ученые собрали два типа образцов: первый в зоне загрязнения, а второй — на расстоянии двух километров от нее. Это позволило сравнить химический и биологический состав почв «пострадавших» и чистых участков.
Чтобы оценить, какие изменения произошли в загрязненных землях, исследователи определили количество гуминовых и фульвокислот — основных компонентов почвенного органического вещества. Эти кислоты активно связывают ионы металлов — в таком виде те гораздо легче растворяются в воде, содержащейся в почве, и далее с ней поступают в ткани растений и животных. Оказалось, что в образцах, взятых из почвы, подверженной антропогенному влиянию, свободных органических кислот было почти в полтора раза больше, поэтому на этих территориях медь образует более подвижные соединения.
Затем ученые вырастили на питательной среде микроорганизмы из проб. Эксперимент показал, что в почвах, в которых содержание меди повышено, количество бактерий снизилось более чем в десять раз. Кроме того, уменьшилась активность ферментов, с помощью которых они получают необходимые для жизнедеятельности вещества из почвы. Такие изменения в микробном составе могут привести к нарушению баланса целой экосистемы и круговорота веществ в ней.
«Наше исследование показало, что увеличение содержания легко окисляемых органических соединений в почве, а также снижение активности ферментов и количества микроорганизмов могут служить признаком загрязнения тяжелыми металлами. Но следует подчеркнуть, что, хотя в загрязненных почвах количество бактерий было ниже, они всё же оставались активны. Значит, микробное сообщество адаптируется к неблагоприятным условиям. В дальнейшем мы планируем определить структурный состав органического вещества почв при загрязнении металлами», — рассказывает руководитель проекта по гранту профессор РНФ Татьяна Минкина, заведующая кафедрой почвоведения и оценки земельных ресурсов ЮФУ.

